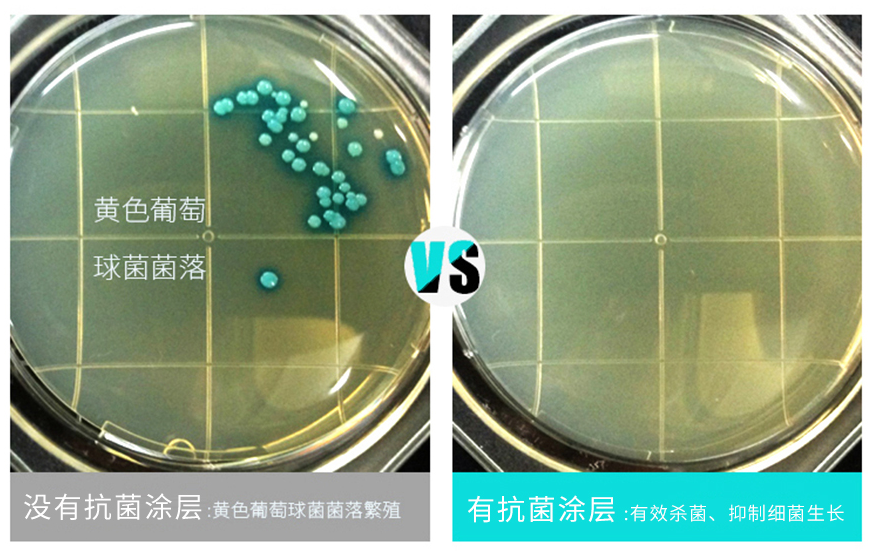

6月17至19日,第二十一届上海国际胶带与薄膜展览会将在上海国家会展中心隆重举行。作为国内胶粘新材与功能膜材知名品牌,及 “十大卫浴优质供应商”之一,安可将携旗下全新产品系列盛装亮相,为观众带来全方位专业的胶带及膜类解决方案。

阻燃胶领衔,多元矩阵一起登场
上海胶带展是全球胶粘新材与功能膜材行业的年度盛会,每年都会吸引来自全球各地的众多客商。
今年,安可将携阻燃胶带、标签产品、玻璃膜、饰面膜等产品,在6.1H馆6A262展位高调登场,并打造一个“绿色主题互动展区”,用创新科技与多元矩阵,为3C电子、新能源、家居装饰等行业,提供“安全化+定制化”解决方案。

其中最值得期待的,是安可打破传统阻燃技术壁垒,以独家特殊配方研制而成的科技型阻燃胶带。该系列以卓越的阻燃、防水、密封、自粘性能,重新定义行业安全标准,并让复杂、高要求的胶粘难题迎刃而解,被不少客户视为守护工程安全的“终极铠甲”!

五大王牌,赋能家居装饰产业
在家居装饰领域,安可更是构建出五大王牌膜类矩阵,包括防爆膜、降温膜、改色膜、装饰膜和抗菌膜。
防爆膜在淋浴房行业得到广泛应用,拥有超强的抗冲击性能,可以在玻璃意外发生破碎时,牢牢黏住碎片,有效防止玻璃飞溅伤人,为家庭筑起一道坚固的安全防线。

降温膜能够精准拦截99.9%的紫外线和红外线,可以在降低室内温度的同时,减少空调的使用频率,并降低能耗。

改色膜拥有丰富的色彩与纹理选择,只需轻轻一贴,就能为橱柜和浴室柜等产品披上新的外衣,令其拥有炫酷的金属质感,或清新自然的木纹纹理,又或者其他更急独特的艺术效果。

装饰膜则以精致的图案与细腻的质感,成为商用空间和家居厨卫新宠,无论酒店厨房高端大气的商务风格,还是商场时尚现代的潮流格调,亦或是温馨浪漫的家居空间,都能轻松驾驭。

还有采用特殊抗菌技术的抗菌膜,能有效抑制3000 +种细菌滋生,无论是用在医院厨房、学校卫浴等公共场所,还是家庭厨卫空间,都可以有效抑菌,为我们创造一个健康洁净的环境。
坚持创新驱动,探索科技无限可能
作为一家专业的材料企业,安可自创立以来,始终以创新研发为核心驱动力,深耕胶粘与薄膜材料领域十余年,并倾力打造了三大先进研发中心与高分子研发实验室,以此不断探索胶带与薄膜产品的全新可能。

发展至今,安可已掌握上百项发明专利,并积极参与行标、国标的起草制定,与3C电子、新能源、家居装饰等领域的众多知名企业建立深度合作,用材料科技为合作伙伴赋能。

当最新阻燃技术遇上行业权威展会,当安全化遇上多元化、定制化,安可给行业带来的远不止安全,而是全新解决方案,以及全新的发展路径。6月17至19日,安可诚邀莅临上海国家会展中心· 6.1H-6A262展位,一起探索材料科技的无限可能!
评论